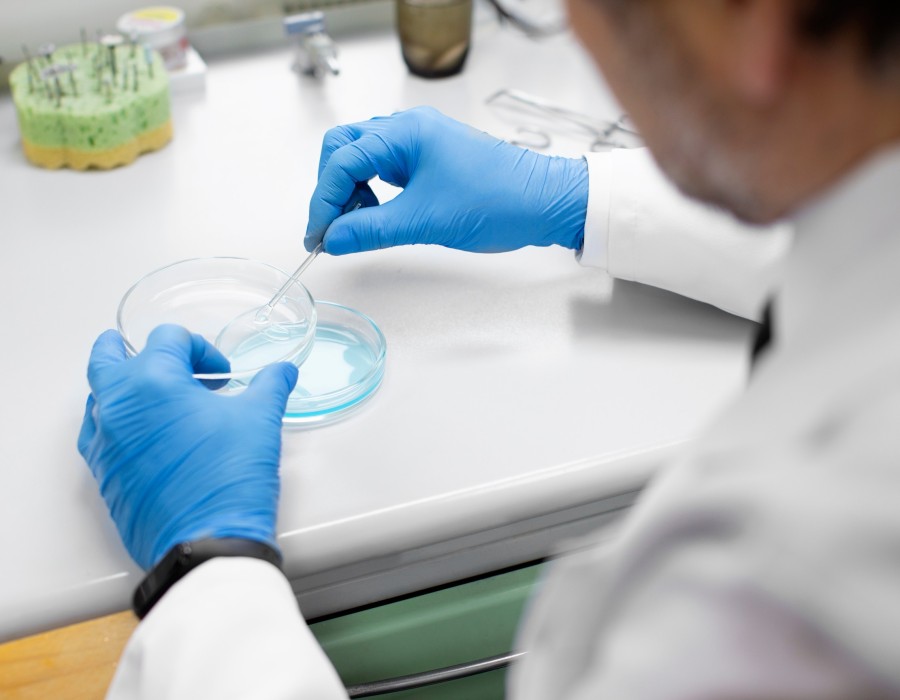

Thinking of starting your family using IVF with a sperm donor in Melbourne? Dr Daniel Lantsberg and his team offer inclusive, supportive fertility care for all. Whether you're a single woman, LGBTQ+ couple, or facing male fertility issues, our sperm donor clinic helps make parenthood possible. Choose from a wide range of donor profiles, and let our experienced team guide you through IVF every step of the way. We combine the latest science with personal care—because your dreams matter. Explore your options today and take control of your journey to becoming a parent.
- Abuse & The Abuser
- Achievement
- Activity, Fitness & Sport
- Aging & Maturity
- Altruism & Kindness
- Atrocities, Racism & Inequality
- Challenges & Pitfalls
- Choices & Decisions
- Communication Skills
- Crime & Punishment
- Dangerous Situations
- Dealing with Addictions
- Debatable Issues & Moral Questions
- Determination & Achievement
- Diet & Nutrition
- Employment & Career
- Ethical dilemmas
- Experience & Adventure
- Faith, Something to Believe in
- Fears & Phobias
- Friends & Acquaintances
- Habits. Good & Bad
- Honour & Respect
- Human Nature
- Image & Uniqueness
- Immediate Family Relations
- Influence & Negotiation
- Interdependence & Independence
- Life's Big Questions
- Love, Dating & Marriage
- Manners & Etiquette
- Money & Finances
- Moods & Emotions
- Other Beneficial Approaches
- Other Relationships
- Overall health
- Passions & Strengths
- Peace & Forgiveness
- Personal Change
- Personal Development
- Politics & Governance
- Positive & Negative Attitudes
- Rights & Freedom
- Self Harm & Self Sabotage
- Sexual Preferences
- Sexual Relations
- Sins
- Thanks & Gratitude
- The Legacy We Leave
- The Search for Happiness
- Time. Past, present & Future
- Today's World, Projecting Tomorrow
- Truth & Character
- Unattractive Qualities
- Wisdom & Knowledge

Comments